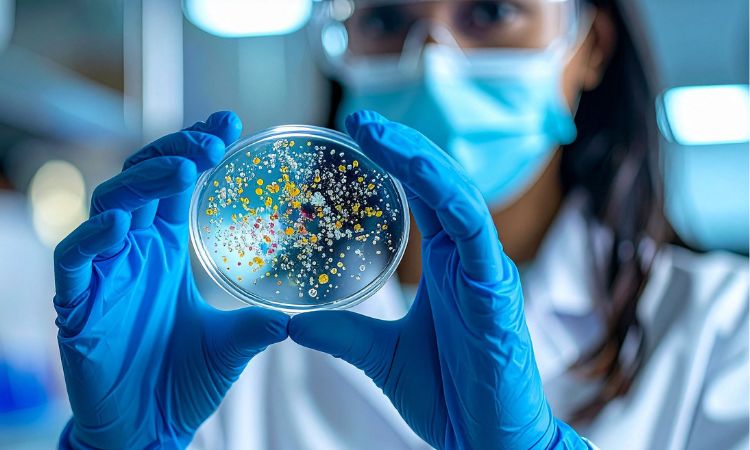
medios de cultivo microbiológico

Los medios de cultivo microbiológico son herramientas fundamentales para el estudio y análisis de microorganismos en distintos contextos científicos y sanitarios. En este blog hablaremos de qué son, para qué se utilizan, cuáles son los más comunes en microbiología y por qué resultan tan importantes en el trabajo diario del/la profesional de la salud y del laboratorio.
Índice de contenidos
¿Qué es un medio de cultivo microbiológico?
Un medio de cultivo microbiológico es una preparación que contiene los nutrientes necesarios para permitir el crecimiento, aislamiento y observación de microorganismos como bacterias, hongos o levaduras. Estos medios pueden presentarse en estado sólido, semisólido o líquido, dependiendo del objetivo del análisis.
Su función principal es recrear, de manera controlada, las condiciones que los microorganismos necesitan para desarrollarse. Gracias a ello, el/la microbiólogo/a, el/la enfermero/a o el/la analista puede identificar características específicas como la morfología, el tipo de metabolismo o la respuesta frente a determinados compuestos.
Importancia de los medios de cultivo en microbiología
El uso correcto de los medios de cultivo microbiológico permite detectar agentes infecciosos, evaluar la calidad microbiológica de alimentos y comprender el comportamiento de microorganismos en diferentes entornos.
Además, son esenciales para:
- El diagnóstico microbiológico
- El control sanitario
- La investigación científica
- El desarrollo biotecnológico
Por esta razón, su selección y preparación deben realizarse con precisión y bajo condiciones adecuadas de esterilidad.
¿Cuáles son los medios de cultivo más utilizados en microbiología?
Existen distintos tipos de medios, cada uno con una función específica. Algunos de los más utilizados son:
Medios de cultivo simples
Son aquellos que permiten el crecimiento de microorganismos poco exigentes. Contienen nutrientes básicos y se emplean como punto de partida en muchos análisis microbiológicos.
Medios de cultivo enriquecidos
Estos medios de cultivo microbiológico incluyen sustancias adicionales como sangre o suero, lo que favorece el desarrollo de microorganismos más exigentes desde el punto de vista nutricional.
Medios selectivos
Están diseñados para inhibir el crecimiento de ciertos microorganismos y permitir el desarrollo de otros. Son muy útiles cuando se necesita aislar un tipo específico dentro de una muestra mixta.
Medios diferenciales
Permiten distinguir microorganismos según su comportamiento metabólico, como la fermentación de ciertos azúcares, lo cual facilita su identificación.
Aplicaciones prácticas en el entorno profesional
En el trabajo cotidiano del/la enfermero/a, del/la técnico/a o del/la profesional del laboratorio, los medios de cultivo microbiológico representan una herramienta clave para la toma de decisiones clínicas y sanitarias.
Su correcta interpretación contribuye a mejorar la prevención, el diagnóstico oportuno y el control de riesgos biológicos, aspectos esenciales para la seguridad y la salud pública.
Formación y actualización profesional
Para quienes desean profundizar en el área biotecnológica, la formación continua es una opción cada vez más valorada. El Máster en Biotecnología Alimentaria se presenta como una alternativa académica orientada a ampliar conocimientos en microbiología y procesos biotecnológicos.
Estudiar en modalidad online ofrece ventajas como la flexibilidad horaria, el acceso desde cualquier lugar y la posibilidad de compatibilizar el aprendizaje con la actividad profesional, lo que resulta especialmente útil para quienes buscan seguir creciendo sin descuidar otras responsabilidades.